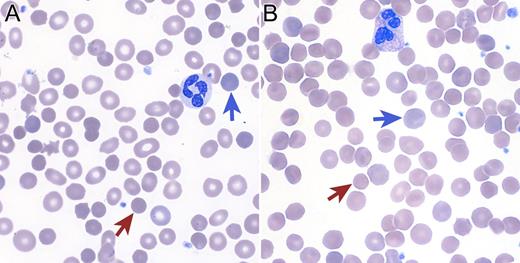
A 73-year-old man without prior personal or family history of anemia developed a chronic hemolytic anemia characterized by an absolute reticulocyte count of 347 000/mm3 (13%) and spherocytic red-cell morphology (see panel A). Antiglobulin testing was negative but osmotic fragility testing was positive. Bone marrow biopsy was hypercellular with a decreased M:E ratio and dysplastic erythroid precursors. Standard cytogenetics reported an interstitial deletion of 5q13-33 and a gain of material on 14q22. High-density single-nucleotide polymorphism array–based karyotyping revealed 6 deletion regions on chromosome 5 and 3 deletion regions on chromosome 14, including loss of 14q23.1-24.2. Taken together with the cytogenetic studies, a complex rearrangement of chromosomes 5 and 14 resulted in the net losses. One of the 14q-deletion regions contains SPTB, rendering this patient haploinsufficient for the gene encoding the β-spectrin protein. Thus, this patient’s complex rearrangement resulted in a phenocopy of hereditary spherocytosis type 2 (OMIM 182870) (see panel B). This patient’s case demonstrates the clinical utility of high-density array karyotyping to define atypical clinical presentations and highlights the variable natural history of myelodysplastic syndromes. / (Panel A) Blood smear from a 73-year-old man with a myelodysplastic syndrome and acquired spherocytosis. (Panel B) Blood smear from a 65-year-old man with autosomal-dominant hereditary spherocytosis. Red arrows indicate microspherocytes and blue arrows indicate polychromatophilic cells (reticulocytes).

A 73-year-old man without prior personal or family history of anemia developed a chronic hemolytic anemia characterized by an absolute reticulocyte count of 347 000/mm3 (13%) and spherocytic red-cell morphology (see panel A). Antiglobulin testing was negative but osmotic fragility testing was positive. Bone marrow biopsy was hypercellular with a decreased M:E ratio and dysplastic erythroid precursors. Standard cytogenetics reported an interstitial deletion of 5q13-33 and a gain of material on 14q22. High-density single-nucleotide polymorphism array–based karyotyping revealed 6 deletion regions on chromosome 5 and 3 deletion regions on chromosome 14, including loss of 14q23.1-24.2. Taken together with the cytogenetic studies, a complex rearrangement of chromosomes 5 and 14 resulted in the net losses. One of the 14q-deletion regions contains SPTB, rendering this patient haploinsufficient for the gene encoding the β-spectrin protein. Thus, this patient’s complex rearrangement resulted in a phenocopy of hereditary spherocytosis type 2 (OMIM 182870) (see panel B). This patient’s case demonstrates the clinical utility of high-density array karyotyping to define atypical clinical presentations and highlights the variable natural history of myelodysplastic syndromes.
(Panel A) Blood smear from a 73-year-old man with a myelodysplastic syndrome and acquired spherocytosis. (Panel B) Blood smear from a 65-year-old man with autosomal-dominant hereditary spherocytosis. Red arrows indicate microspherocytes and blue arrows indicate polychromatophilic cells (reticulocytes).
A 73-year-old man without prior personal or family history of anemia developed a chronic hemolytic anemia characterized by an absolute reticulocyte count of 347 000/mm3 (13%) and spherocytic red-cell morphology (see panel A). Antiglobulin testing was negative but osmotic fragility testing was positive. Bone marrow biopsy was hypercellular with a decreased M:E ratio and dysplastic erythroid precursors. Standard cytogenetics reported an interstitial deletion of 5q13-33 and a gain of material on 14q22. High-density single-nucleotide polymorphism array–based karyotyping revealed 6 deletion regions on chromosome 5 and 3 deletion regions on chromosome 14, including loss of 14q23.1-24.2. Taken together with the cytogenetic studies, a complex rearrangement of chromosomes 5 and 14 resulted in the net losses. One of the 14q-deletion regions contains SPTB, rendering this patient haploinsufficient for the gene encoding the β-spectrin protein. Thus, this patient’s complex rearrangement resulted in a phenocopy of hereditary spherocytosis type 2 (OMIM 182870) (see panel B). This patient’s case demonstrates the clinical utility of high-density array karyotyping to define atypical clinical presentations and highlights the variable natural history of myelodysplastic syndromes.
(Panel A) Blood smear from a 73-year-old man with a myelodysplastic syndrome and acquired spherocytosis. (Panel B) Blood smear from a 65-year-old man with autosomal-dominant hereditary spherocytosis. Red arrows indicate microspherocytes and blue arrows indicate polychromatophilic cells (reticulocytes).
For additional images, visit the ASH IMAGE BANK, a reference and teaching tool that is continually updated with new atlas and case study images. For more information visit http://imagebank.hematology.org.